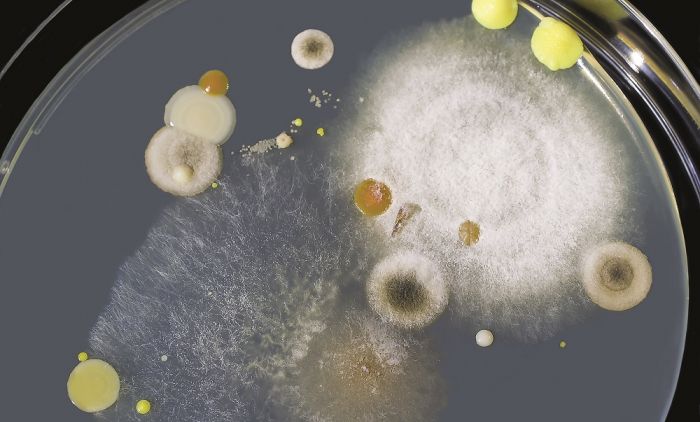

Opasna bolnička gljivica pojavila se izvan zdravstvenih ustanova!
Smrtonosna bolnička supergljivica, otporna na postojeće antifungalne lekove, otkrivena je prvi put izvan bolnice, na plaži izolovanog tropskog ostrva.
Pročitajte još: Poboljšava varenje, utiče na zdravlje kostiju... Zašto treba da zavolimo KEFIR?
Radi se o gljivici kandidi auris, koja se misteriozno pojavila u bolnicama pre više od 10 godina. Kandida auris prvi put je otkrivena 2009. godine na pacijentu u Japanu.
Mikrob može da uzrokuje infekcije krvotoka, pogotovo kod pacijenata koji zahtevaju katetere i cevčice za disanje ili hranjenje. Infekcije njome je teško lečiti, jer je otporna na mnoge antifungalne lekove, a može da se zadrži i na površinama.
Pročitajte još: Moćni sastojak ĐUMBIRA ima jako delovanje u borbi protiv infekcija: Zašto bi češće trebalo da se nađe na meniju?
Ako se potvrdi da je gljivica zaista stigla iz prirode u bolnice i da je globalno zagrevanje imalo uticaja na njen prelaz na čoveka, porašće i zabrinutost da bi to isto mogli da učine i ostali patogeni.
Pratite nas na INSTAGRAMU i FEJSBUKU
























